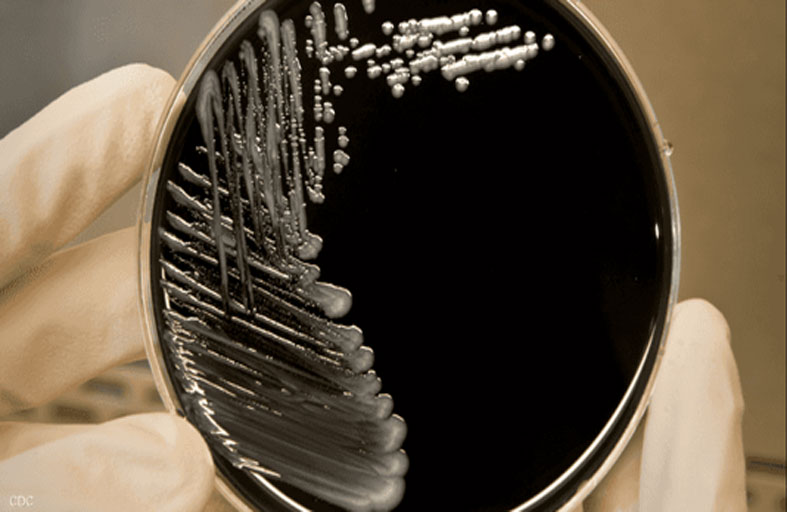
واقعة الحديقة تحول حياة امرأة إلى مأساة

محمد بن زايد ومحمد بن راشد: تمنياتنا بمستقبل مشرق لشعبنا وسلام واستقرار للعالم
بانوراما
بعد 20 عاما.. حل لغز جريمة هزت الأردن
كشف البحث الجنائي في الأردن ملابسات جريمة قتل بشعة وقعت عام 2003، حيث فتحت فرق التحقيق في القضايا المجهولة ملف القضية وتوصلت للقتلة بعد 20 عاما على الواقعة. وفي تفاصيل الجريمة التي هزت ... إقرأ المزيد
صيد الأسماك يخفّف المشاكل النفسية
أظهرت دراسة استقصائية جديدة أجريت في بريطانيا أن الصيد الترفيهي يساعد من يعانون من مشاكل خطيرة في الصحة النفسية، كونه يجمع بين الاسترخاء والنشاط البدني وإعادة توجيه الاهتمام والاستمتاع. وأجريت الدراسة في جامعة ... إقرأ المزيد
عائلة تخفض نفقات الطعام بطريقة مذهلة
نجحت عائلة بريطانية في تجاوز أزمة غلاء المعيشة عن طريق البحث عن جميع وجباتها في البراري القريبة من منزلها، إذ تقلصت نفقاتها إلى 6 دولارات فقط في الشهر. اكتشف جيم بارومز، 32 عاماً، ... إقرأ المزيد
هاتف ذكي لكبار السن من غيغاست
أطلقت شركة غيغاست هاتفها الذكي GS5 senior الجديد، الذي يستهدف كبار السن بصفة خاصة، بسعر يبلغ 299 يورو.وأوضحت الشركة الألمانية أن هاتفها الذكي GS5 senior الجديد يمتاز بواجهة استخدام بسيطة وسهلة الاستخدام ... إقرأ المزيد
الصحة العالمية تغير اسم جدري القرود
أعلنت منظمة الصحة العالمية، أنها ستبدأ في استخدام اسم جديد مفضل هو "إم بوكس" كمرادف لجدري القرود، وحثت الآخرين على أن يحذوا حذوها بعد تلقي شكاوى من أن الاسم الحالي للمرض ينطوي ... إقرأ المزيد
تغير المناخ يهدد تربية النحل في غزة
لم يسلم النحل المُنتج للعسل في غزة من تبعات تغير المناخ، لأن الأمطار والرياح أبقت النحل داخل الخلايا، خلال الربيع الماضي، في حين كان يُفترض أن ينشط بحثا عن الرحيق. ويقول وليد أبو ... إقرأ المزيد
ويل سميث يتحدث عن صفعة الأوسكار
أعرب النجم الأمريكي، الفائز بجائزة الأوسكار، ويل سميث عن قلقه حيال موقف الجمهور تجاه فيلمه الجديد "التحرر" "Emancipation" وما ارتبط في أذهانهم منذ صفعة الأوسكار التي وجهها لمقدم حفل الأوسكار كريس روك، ... إقرأ المزيد
مادونا تشارك صورة لأبنائها في عيد الشكر
احتفلت نجمة البوب مادونا "64 عاماً"، بعيد الشكر هذا العام بحضور أبنائها الستة مجتمعين. وأظهرت صور الاحتفال التي تم نشرها على إنستغرام، أبناء مادونا: لورديس ليون "26 عاماً"، روكو ريتشي "22 عاماً"، ديفيد ... إقرأ المزيد
© 2013 جميع الحقوق محفوظة لجريدة الفجر.